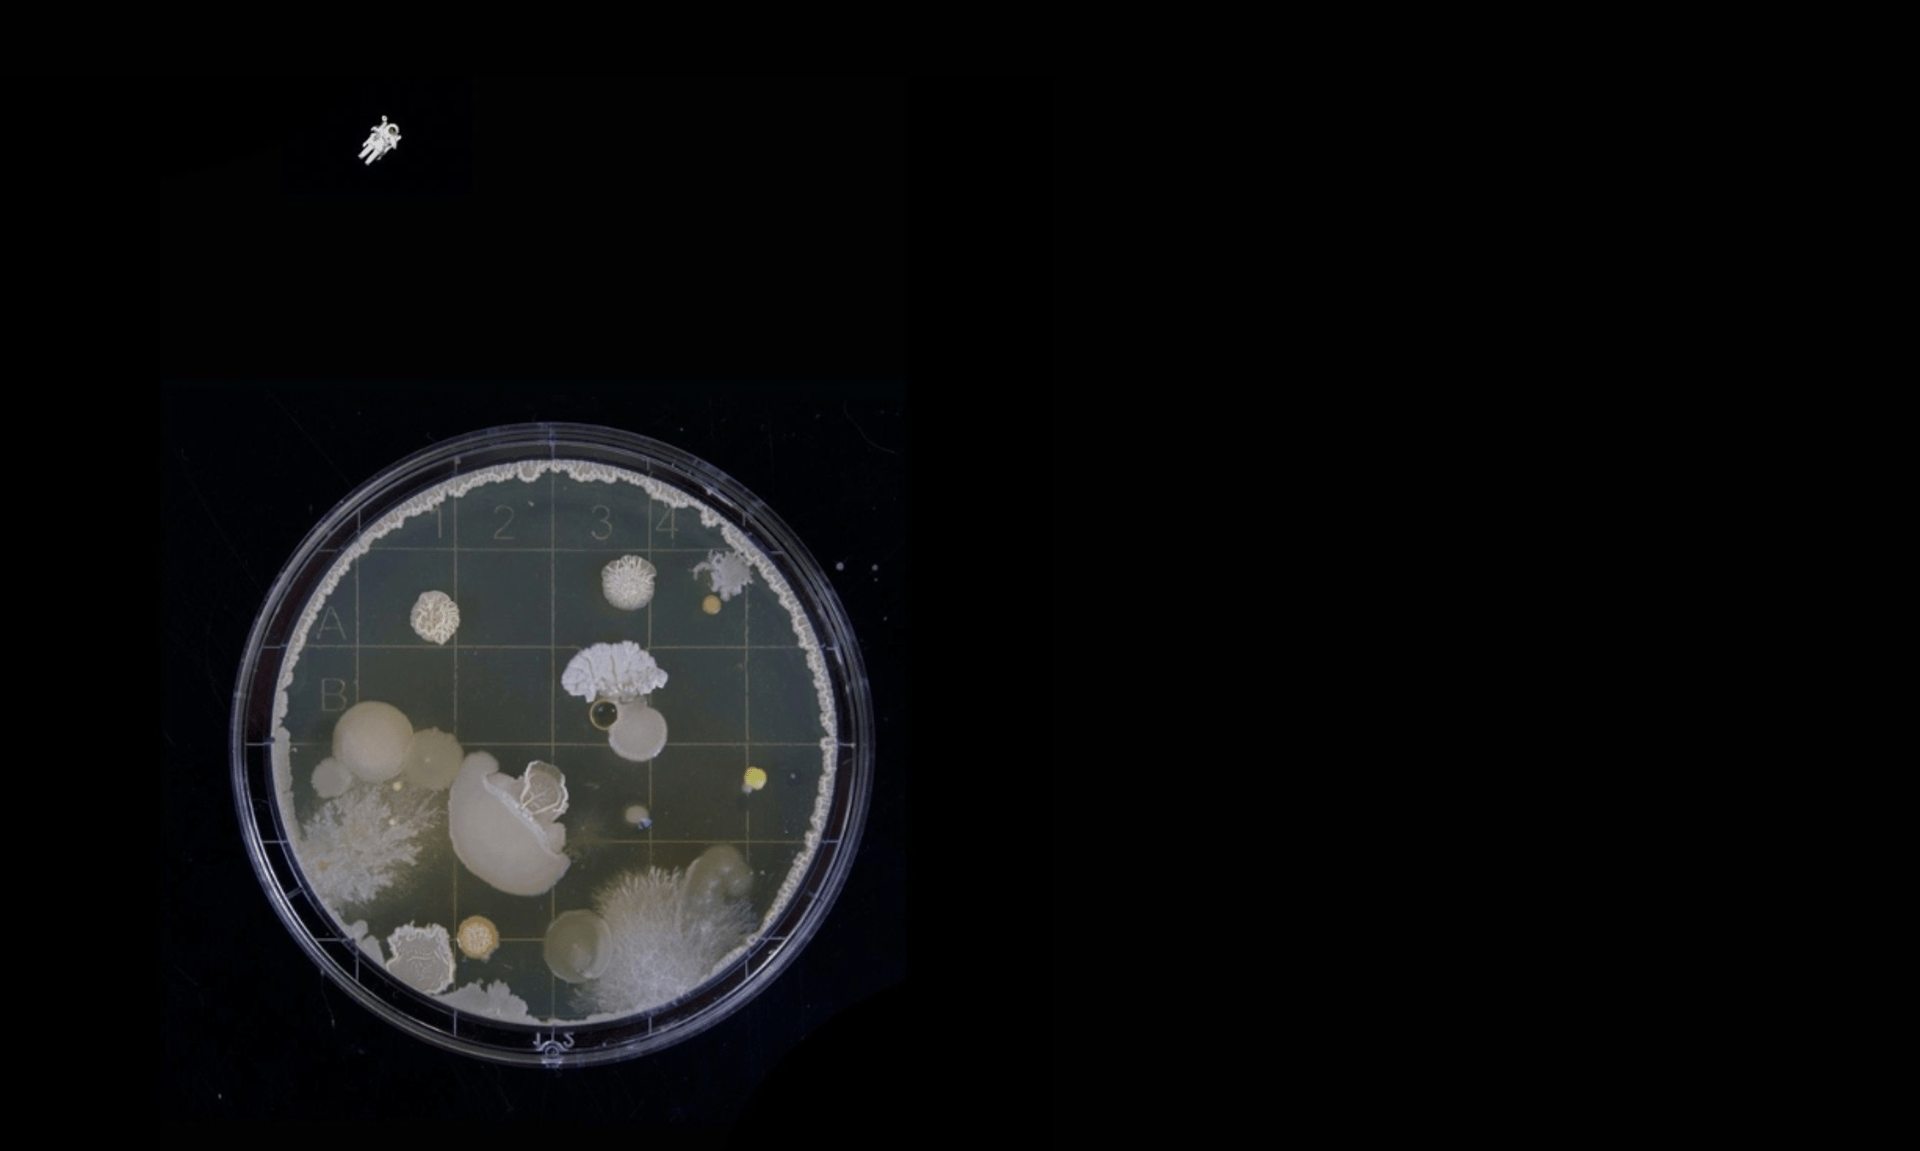

LEB! & ||:epicycle:||

My post content
the 1st concert
11.10.2022 20.00 Zentralbibliothek Essen / Eintrittsfrei
LEB!
Areum Lee
tickle tickle (2020)
für Kontrabass solo
Jieun Jun
VO (2022), UA
für Quintett
Jennifer Walshe
as mo cheann (2000)
für Stimme und Geige
Jieun Jun
Klavier pur (2020)
für Klavier solo
Areum Lee
Event horizon (2022), UA
für Quintett
the 2st concert
17.10.2022 19.30 Bürgermeisterhaus Essen-Werden / 10(5) Euro
||:epicycle:||
Mark Andre
iv 17 (2019)
für Sopran und Klavier
Jani Christou
Epicycle (1986)
Betsy Jolas
B for Sonata (1973)
für Klavier solo
Deok-Vin Lee
Outs (2018)
für drei Performer, Licht, mechanische Relais und Elektronik
Deok-Vin Lee
up to (2022)
für einen Performer
Chanhee Lim
:|| (2002), UA
für einen Performer, verstärkte Objekte und Live-Elektronik
Simon Steen-Andersen
Study for String Instrument #1 (2007)


project ensemble morph
Dirigentin, Performer

